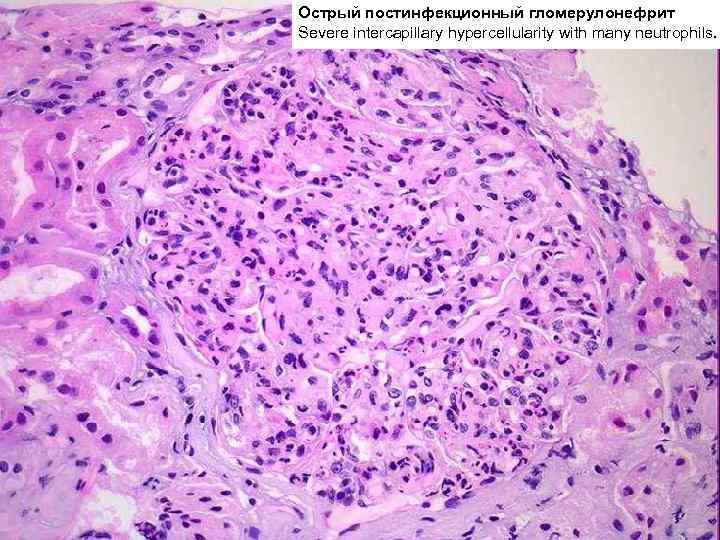
Острый постинфекционный гломерулонефрит Severe intercapillary hypercellularity with many neutrophils.
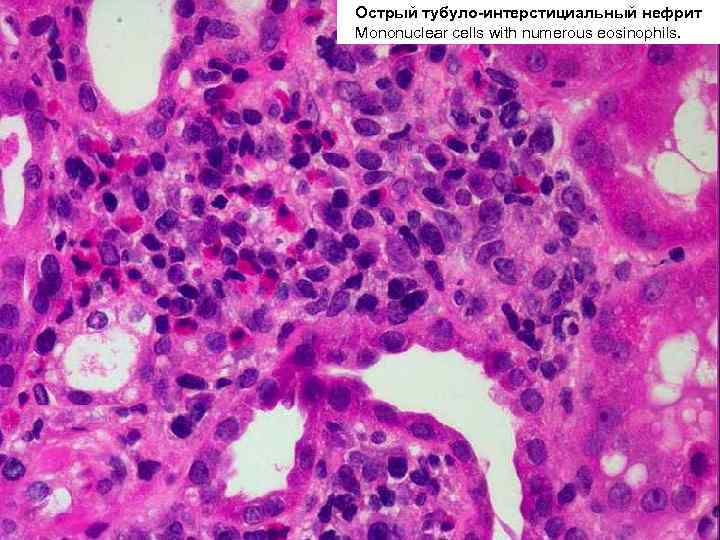
Острый тубуло-интерстициальный нефрит Mononuclear cells with numerous eosinophils.

БОЛЕЗНИ ПОЧЕК.ppt
- Количество слайдов: 132

БОЛЕЗНИ ПОЧЕК

Болезни почек принято делить на две большие группы: n нефропатии; n другие заболевания почек. Нефропатии представляют собой заболевания, в основе которых лежит двустороннее диффузное поражением почек. Исходя из структурнофункционального принципа, их разделяют на: v v гломерулопатии; тубулопатии.

Нормальный почечный клубочек

Нормальный почечный клубочек

ГЛОМЕРУЛОПАТИИ Это группа заболеваний характеризуется первичным поражением клубочкового аппарата почек, как структурным ¨ воспаление, ¨ клеточная пролиферация, ¨ утолщение базальной мембраны, ¨ фиброз, нарушение структуры эпителиальных клеток, так и функциональным ¨ (повышенная проницаемость является причиной протеинурии и гематурии клубочкового происхождения).

ГЛОМЕРУЛОПАТИИ У больных могут наблюдаться следующие симптомы: n Мочевой синдром: рецидивирующая безболевая синдром гематурия, которая может варьировать от макрогематурии до микрогематурии, определяемой только при специальных исследованиях, олигурия, протеинурия, цилиндрурия. n Гипертензия — повышение артериального давления. У таких больных часто наблюдаются боли в пояснице и головные боли. Нефротический синдром, характеризующийся тяжелой синдром протеинурией и, как следствие, гипоальбуминемией, что приводит к развитию выраженных отеков. n

Повреждение клубочков может быть: n фокальным (очаговым) при котором поражается часть клубочков, при этом другие клубочки остаются нормальными; диффузным, когда поражаются все клубочки; n глобальным: когда поражается весь n клубочек; n сегментарным: когда поражается только часть клубочка.

Имеется несколько типов морфологических изменений, которые могут комбинироваться при различных заболеваниях. К ним относятся: Пролиферация клеток в клубочках. Все клетки, входящие в состав клубочка, могут пролиферировать при различных патологических состояниях. n Пролиферация мезангиальных клеток выявляется в виде увеличения количества ядер (более трех) в центральной части клубочковой дольки. Мезангиальные клетки участвуют в процессах фагоцитоза в клубочке. v Пролиферация эндотелиальных клеток приводит к облитерации просвета сосудов. v Пролиферация эпителиальных клеток, при значительной ее выраженности, приводит к формированию масс клеток в виде полулуний, что приводит к облитерации просвета капсулы Боумена. v

Инфильтрация клубочков клетками воспаления: Острое воспаление сопровождается n экссудацией жидкости и отеком клубочков (“экссудативный гломерулонефрит”). Утолщение базальной мембраны капилляров: Повышение количества структурных n материалов в базальной мембране при световой микроскопии выявляется в виде утолщения стенки капилляров. Утолщение мембраны связано с накоплением в ней иммунных комплексов, иммуноглобулинов и комплемента. Накапливаться они могут: v субэпителиально; v внутри мембраны; v субэндотелиально.

Увеличение межклеточного вещества в мезангиуме наблюдается при отложении n иммуноглобулинов и комплемента в мезангиуме. n Слияние отростков подоцитов: Это неспецифическое изменение происходит, как предполагается, в результате повышенного выхода белков из капилляров клубочков. n Фиброз (склероз) может быть либо сегментарным (мезангиум, пространство Боумена), либо глобальным.

Патогенез гломерулонефритов Повреждения клубочков могут иметь иммунные или неиммунные механизмы. Иммунное повреждение клубочков n действие нефротоксических антител ¨ антитела против базальной мембраны (анти. БМК антитела) ¨ антитела против не-БМК антигенов n отложение иммунных комплексов.

Медиаторы повреждения клубочков n Комплемент Нефритические факторы (Ne. F-AP и Ne. F-CP) n n Полиморфноядерные лейкоциты n Факторы свертывания крови От сочетания различных медиаторов зависит гистологический тип повреждения при гломерулонефритах.

Классификация гломерулопатий n Врожденные гломерулонефриты Наследственный нефрит (синдром Альпорта) v Врожденный нефротический синдром v n Первичные приобретенные гломерулонефриты v v v v n n n Гломерулонефрит с минимальными изменениями Постинфекционный (постстрептококковый) гломерулонефрит Подострый (полулунный) гломерулонефрит Синдром Гудпасчера Мезангиопролиферативный гломерулонефрит Мембранозный гломерулонефрит Мембранопролиферативный (мезангиокапиллярный) гломерулонефрит Очаговый гломерулосклероз Вторичные приобретенные гломерулонефриты Хронический гломерулонефрит Другие гломерулярные заболевания Диабетическая нефропатия v Амилоидоз v

Очаговый гломерулонефрит One glomerulus with segmental necrosis Silver stain.

Очаговый гломерулонефрит

Очаговый гломерулонефрит

Синдром Альпорта n Врожденное гломерулярное заболевания, при котором нефрит сочетается с дегенерацией слухового нерва и катарактой. n Наблюдается очень редко.

Синдром Альпорта Interstitial foam cells Masson stain.

Синдром Альпорта Segmental glomerular sclerosis and interstitial foam cells Masson stain.

Синдром Альпорта

Синдром Альпорта

Синдром Альпорта

Очаговый сегментарный гломерулярный склероз n является причиной нефротического синдрома у 10% детей и 15% взрослых.

Очаговый сегментарный гломерулярный склероз

Очаговый сегментарный гломерулярный склероз (ранние поражения)

Очаговый сегментарный гломерулярный склероз (ранние поражения)

Очаговый сегментарный гломерулярный склероз (поздние поражения)

Очаговый сегментарный гломерулярный склероз (поздние поражения)

Очаговый сегментарный гломерулярный склероз с гиалинозом Focal and segmental hyalin change Trichrome.

Очаговый сегментарный гломерулярный склероз с гиалинозом Collapsing glomerular capillaries with prominent podocytes Trichrome stain.

Очаговый сегментарный гломерулярный склероз с гиалинозом Segmental sclerosis Silver positive and hyalinosis Silver negative.

По характеру течения гломерулонефриты делят на: постинфекционный (острый диффузный пролиферативный); n быстропрогрессирующий, злокачественный (подострый); n хронический. n
Острый постинфекционный гломерулонефрит Severe intercapillary hypercellularity with many neutrophils.

Быстропрогрессирующий (подострый) гломерулонефрит n n характеризуется: наличием более чем в 70% клубочков эпителиальных полулуний. Полулуния, заполняющие капсулу Боумена, состоят из эпителиальных клеток и макрофагов, пролиферирующих в ответ на выпот фибрина из поврежденных клубочков. Полулуния представляют собой необратимое повреждение клубочка, приводящее к его склерозированию. В полулуниях обязательно находят фибрин, который, как предполагается, и является причиной их образования. быстрой прогрессией

Полулунный гломерулонефрит

Полулунный гломерулонефрит

Полулунный гломерулонефрит

Полулунный гломерулонефрит diffuse crescentic glomerular nephritis

Полулунный гломерулонефрит Fibrocellular crescent.

Полулунный гломерулонефрит Cellular crescent with compressed and disrupted glomerulus capillaries Silver stain.

Полулунный гломерулонефрит Cellular crescent with segmental necrosis of glomerulus Silver stain.

Полулунный гломерулонефрит Fibrous crescent with only a few myofibroblasts present PAS stain.

Причины развития быстро прогрессирующего гломерулонефрита n Постинфекционный ¨ ¨ ¨ n Полиорганные заболевания ¨ ¨ ¨ ¨ n Постстрептококковый гломерулонефрит Нестрептококковый гломерулонефрит Инфекционный эндокардит Синдром Гудпасчера Системная красная волчанка Пурпура Шенляйн-Геноха Болезнь Бергена (Ig. A нефропатия) Узелковый периартериит Гранулематоз Вегенера Мембранопролиферативный гломерулонефрит Идиопатический ¨ ¨ ¨ Тип I: с анти-БМК антителами (20%) Тип II: с иммунными комплексами (30%) Тип III: иммунонеактивный (50%)

Синдром Гудпасчера

Синдром Гудпасчера

Синдром Гудпасчера

Узелковый периартериит Circumscribed necrosis of small artery.

Узелковый периартериит Segmental necrosis of an artery with inflammation.

Узелковый периартериит Arterial wall remodeling with elastic membrane disruption VVG stain.

Узелковый периартериит Cellular crescent with segmental necrosis of glomerulus Silver stain.

Гломерулонефрит с иммунными комплексами Nodular mesangial sclerosis Silver stain.

Гломерулонефрит с иммунными комплексами Nodular mesangial expansion and tubular basement membrane thickening PAS stain.

Криоглобулиновый гломерулонефрит Capillary lumina occluded by hyalin thrombi.

Хронические гломерулонефриты делятся на: n мезангиопролиферативный n мембранозный n мембранопролиферативный или мезангиокапиллярный ¨ тип I (с субэндотелиальными отложениям) ¨ тип II (“болезнь плотных отложений”)

Мезангиопролиферативный гломерулонефрит n n классифицируют на основе доминирующего иммуноглобулина, накапливающегося в клубочке. Наиболее часто в мезангиуме накапливается Ig. G и С 3. Накопление Ig. A наблюдается при пурпуре Шенляйн-Геноха, системном васкулите с вовлечением почек. Известно всего лишь одно заболевание, имеющее фокальный тип поражения почек, при котором почки поражаются первично — Ig. A нефропатия.

Мезангиопролиферативный гломерулонефрит Non Ig. A/non lupus mesangial immune complex glomerulonephritis

Ig. A нефропатия (болезнь Berger) n Самая распространенная причина хронической почечной недостаточности во всем мире. n При световой микроскопии обнаруживается увеличение количества клеток в мезангиуме и увеличение количества мезангиального вещества. При прогрессировании заболевания развивается склероз. n При иммунофлюоресцентных методах исследования обнаруживается накопление Ig. A в мезангиуме в виде сливающихся между собой отдельных гранул. Также часто обнаруживается С 3.

Болезнь Бергена

Болезнь Бергена

Болезнь Бергена

Болезнь Бергена

Мембранозный гломерулонефрит n 85% больных – идиопатический мембранозный гломерулонефрит. Наиболее частыми причинами вторичного мембранозного гломерулонефрита являются: n n n инфекционные — сифилис, малярия, гепатит В, шистосомиаз, лепра; лекарственные — пеницилламин, золото, ртуть, героин; опухоли — злокачественные лимфомы, лимфома Ходжкина, бронхогенный рак легкого; системные заболевания соединительной ткани (системная красная волчанка, прогрессирующий системный склероз; другими состояниями (серповидно-клеточная анемия).

Мембранозный гломерулонефрит Diffusely thickened glomerular capillary loops.

Мембранозный гломерулонефрит Diffusely thickened glomerular capillary loops PAS stain.

Мембранозный гломерулонефрит Silver positive spikes and basement membrane vacuoles in glomerular capillaries.

Мембранопролиферативный гломерулонефрит n характеризуется наличием двух признаков: утолщения стенки капилляров и пролиферации мезангиальных клеток. n Тип I МПГН (мезангиокапиллярным гломерулонефритом, с субэндотелиальными отложениям) обусловливается иммунокомплексным повреждением; Тип II МПГН (“болезнь плотных отложений”) связан с активацией комплемента по альтернативному пути без участия иммунных комплексов. n


Мембранопролиферативный гломерулонефрит

Мембранопролиферативный гломерулонефрит Hypercellular lobulated glomerulus PAS stain.

Мембранопролиферативный гломерулонефрит

Мембранопролиферативный гломерулонефрит (поздняя стадия)

Болезнь плотных отложений Mesangial expansion and frequent double contour of capillaries Silver stain.

Болезнь плотных отложений

ВТОРИЧНЫЕ ПРИОБРЕТЕННЫЕ ГЛОМЕРУЛОПАТИИ Вторичные гломерулонефриты могут быть обусловлены: n иммунокомплексным повреждением (системная красная волчанка, пурпура Шенляйн-Геноха) n метаболическими нарушениями (сахарный диабет, почечный амилоидоз) n поражением сосудов (узелковый периартериит, гранулематоз Вегенера, гемолитико-уремический синдром, идиопатическая тромбоцитопеническая пурпура, ДВС-синдром)

Тромботические микроангиопатии Fibrin thrombus Silver stain.

Тромботические микроангиопатии ДВС-синдром Intimal thickening.

Тромботические микроангиопатии ДВС-синдром Ischemic kidney with basement membrane wrinkling PAS stain.

Тромботические микроангиопатии ДВС-синдром Glomerular capillary thrombi and endothelial swelling Silver stain.

Тромботические микроангиопатии ДВС-синдром Intimal thickening, fibrinoid necrosis, and fibrin thrombi.

Тромботические микроангиопатии ДВС-синдром Bloodless glomerulus Silver stain.

Тромботические микроангиопатии ДВС-синдром Vascular and glomerular thrombosis, necrosis, and glomerular congestion.

Тромботические микроангиопатии ДВС-синдром Arterial fibrinoid necrosis with thrombosis.

Тромботические микроангиопатии ДВС-синдром Mucoid intimal thickening.

Категории поражения почек при СКВ по определению ВОЗ Класс Патологические изменения Доля в% Клинические проявления I Нет изменений II Мезангиальный гломерулонефрит 10 III Фокальный пролиферативный гломерулонефрит 30 IV Диффузный пролиферативный гломерулонефрит 50 Тяжелое поражение с быстрой прогрессией в ХПН V Диффузный мембранозный гломерулонефрит 10 Нефротический синдром; медленная прогрессия в ХПН Легкая степень поражения с микрогематурией и протеинурией; медленная прогрессия

Волчаночный нефрит Proliferative lupus nephritis with large capillary loop deposits.

Волчаночный нефрит Large capillary loop deposits wireloop. PAS/MS stain.

Волчаночный нефрит Segmental necrosis and hypercellularity PAS/MS stain.

Волчаночный нефрит Three of four glomeruli with segmental hypercellularity and crescent Silver stain.

Волчаночный нефрит Mild mesangial hypercellularity and expansion PAS stain.

Волчаночный нефрит Proliferation, segmental glomerular hypercellularity and necrosis.

Волчаночный нефрит Cellular crescent and interstitial inflammation PAS stain.

Диабетическая нефропатия Гистологически могут обнаруживаться три типа изменений, которые отражают степень тяжести поражения: n утолщение стенки капилляров на начальных этапах; n увеличение объема мезангиального матрикса, что приводит к сдавлению сосудов клубочка и развитию диффузного гломерулосклероза; n узелковый гломерулосклероз или изменения Киммельстила-Вильсона - узловое увеличение объема мезангиума среди долек клубочка.

Диабетическая нефропатия Bowman's capsule hyaline droplet.

Диабетическая нефропатия Diffuse and nodular diabetic glomerular sclerosis and arteriolar hyalinosis.

Диабетическая нефропатия Silver positive KS nodules.

Диабетическая нефропатия Hyalin lesion fibrin cap in a sclerosing glomerulus PAS stain.

Диабетическая нефропатия Diffuse mesangial expansion PAS stain.

Амилоидоз почек В течении амилоидоза почек различают следующие стадии: n латентную; n протеинурическую; n нефротическую; n азотемическую (уремическую).

Амилоидоз почки Glomerular deposition of pink homogenous material

Амилоидоз почки Silver negative glomerular amyloid deposits Silver stain.

Амилоидоз почки Positive congo red stain depicts glomerular amyloid.

Гемолитико-уремический синдром — это сложное состояние, которое характеризуется: n n n острой нефропатией; гемолизом; тромбоцитопенией. Выделяют три типа ГУС: Ø детский, Ø взрослый Ø вторичный.

ТУБУЛОПАТИИ n заболевания почек с первичным ведущим поражением канальцев, которое сопровождается нарушением их концентрационной, реабсорбционной и секреторной функции. n наследственные тубулопатии (обусловленные различными формами ферментопатий) n приобретенные тубулопатии v острый некротический нефроз v хронические тубулопатии (миеломная и подагрическая почка).

Острый некротический нефроз (ОНН) является наиболее частой причиной острой почечной недостаточности Основные причины ОНН: n n ишемия токсическое поражение ¨ тяжелые металлы; ¨ органические растворители ¨ гликоли ¨ лекарственные вещества (антибиотики, нестероидные противовоспалительные препараты; ртутные диуретики и др. ) ¨ йодсодержащие рентгенконтрастные вещества ¨ фенол ¨ пестициды

ОНН Typical ATN with dilated-appearing tubules and casts.

ОНН Acute stage of ATN with patchy tubular epithelial necrosis and congestion of peritubular capillaries.

ОНН Dilated tubules with flat epithelium and granular debris.

ОНН Dystrophic calcification of a tubule in ATN.

ОНН Regenerating tubules with flattened epithelium in resolving ATN.

Тубуло-интерстициальные заболевания почек, которые характеризуются первичным поражением интерстициума и почечных канальцев. классификация интерстициальных нефритов основана на этиологических факторах: n токсический — в результате действия солей тяжелых n иммунологический; метаболический — (ураты, оксалаты, гипокалиемия, металлов (свинца, ртути, золота и др. ) и некоторых лекарств (гентамицина, цефалоридина, циклоспорина А); n инфекционный (вирусы, бактерии); n нефрокальциноз); n физические — обструкция; n неопластический — миелома.

Острый тубуло-интерстициальный нефрит Mononuclear cells infiltrating interstitium.
Острый тубуло-интерстициальный нефрит Mononuclear cells with numerous eosinophils.

Хронический интерстициальный нефрит Focal scarring with mononuclear cell infiltrate.

Хронический интерстициальный нефрит Mononuclear cell infiltrate localized to scarred area.

Ураты

Оксалаты

Нефрокальциноз

Нефрокальциноз Dystrophic calcification of a tubule in ATN.

Пиелонефрит n инфекционное заболевание, при котором инфекция может попадать в почки гематогенным (нисходящим) или уриногенным (восходящим) путем. острый хронический n n

Острый пиелонефрит Streak-like interstitial inflammation with neutrophilic casts.

Острый пиелонефрит Tubules filled with neutrophils.

Острый пиелонефрит

При остром пиелонефрите могут развиться следующие осложнения: n Некроз сосочков почки. n Пионефроз. n Околопочечный абсцесс. n Эмфизематозный пиелонефрит

Хронический пиелонефрит

Хронический пиелонефрит

Ксантогранулематозный пиелонефрит

Ксантогранулематозный пиелонефрит

Ксантогранулематозный пиелонефрит

Нефросклероз Уплотнение и сморщивание почек вследствие разрастания соединительной ткани n Первичный n Вторичный (исход хронического гломерулонефрита, реже – пиелонефрита и др. ) Нефросклероз любой этиологии ведет к развитию хронической почечной недостаточности

Доброкачественный нефросклероз Fibrous arterial thickening, arteriolar hyalin PAS stain.

Доброкачественный нефросклероз Focal subcapsular scarring.

Доброкачественный нефросклероз Arteriolar hyalin change.
БОЛЕЗНИ ПОЧЕК.ppt